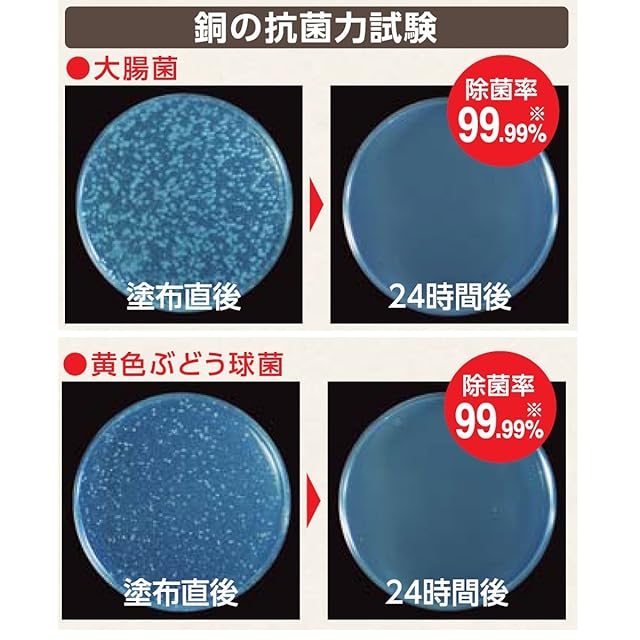

1/4
SANEI(サンエイ) 流し排水栓カゴ ぬめり防止 144mm 銅製 PH691F-3
¥3,275
SOLD OUT
【商品概要】
銅の抗菌効果でヌメリを減らします。銅の抗菌効果でヌメリ・目詰まり・臭いなどの発生を抑制(除菌率99.99%)
ゴミが引っかかりにくいパンチング穴加工なのでお手入れしやすい。
【お手入れ方法】カゴが黒ずんだ時は、酢(家庭用)に同量の塩を混ぜたものを塗り15~30分程置いた後、ブラシでこすりながら水で軽く洗い流します。※使用条件によって黒ずむ場合もありますが、銅イオンの抗菌効果は変わりませんので安心してお使いください。
使用条件によっては若干の緑青が発生する事がありますが、緑青は毒物ではありません。(昭和56年厚生省発表)
【商品詳細】
ブランド:SANEI(サンエイ)
商品種別:排水口水切りカゴ
商品名:SANEI(サンエイ) 流し排水栓カゴ ぬめり防止 144mm 銅製 PH691F-3
製造元:SANEI(旧社名:三栄水栓製作所)
商品番号:PH691F-3
色:黄土色
梱包サイズ:42.4cm
-
レビュー
(5)
最近チェックした商品
同じカテゴリの商品
その他の商品